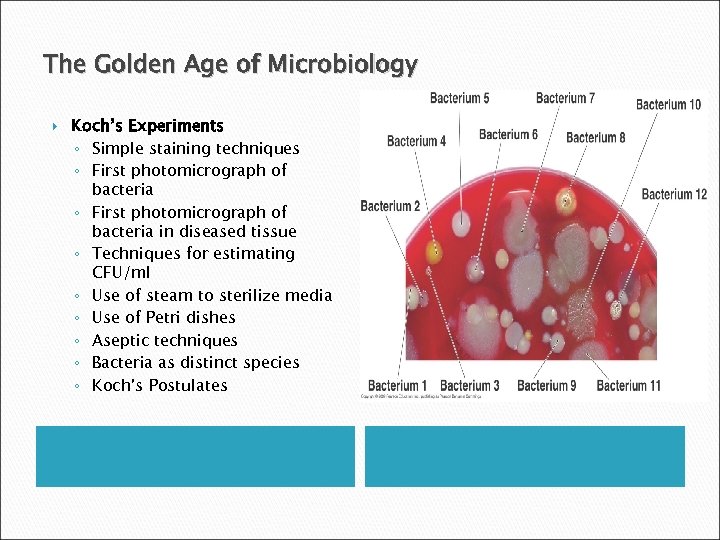
The Golden Age of Microbiology Koch’s Experiments ◦ Simple staining techniques ◦ First photomicrograph

beec9461e662a439e3bb6cf2cdda3e91.ppt
- Количество слайдов: 34

Microbiology for the Health Sciences An Introduction to Microbiology MICROBIOLOGY WITH DISEASES BY BODY SYSTEM SECOND EDITION

The Scope of Microbiology: The study of living things too small to be seen without magnification ◦ Microorganisms or microbesthese microscopic organisms ◦ Commonly called “germs, viruses, agents…” but not all cause disease and many more are useful or essential for human life

Introduction to Microbiology How Can Microbes Be Classified? Carolus Linnaeus (Swedish) developed taxonomic system for naming plants and animals and grouping similar organisms together Leeuwenhoek’s microorganisms grouped into six categories as follows: Fungi Protozoa Algae Bacteria Archaea Small animals

Introduction to Microbiology Fungi ◦ Eukaryotic (have membrane-bound nucleus) ◦ Obtain food from other organisms ◦ Possess cell walls ◦ Composed of Molds – multicellular; have hyphae; reproduce by sexual and asexual spores Yeasts – unicellular; reproduce asexually by budding; some produce sexual spores

Introduction to Microbiology Protozoa ◦ Single-celled eukaryotes ◦ Similar to animals in nutrient needs and cellular structure ◦ Live freely in water; some live in animal hosts ◦ Asexual (most) and sexual reproduction ◦ Most are capable of locomotion by Pseudopodia – cell extensions that flow in direction of travel Cilia – numerous, short, hairlike protrusions that propel organisms through environment Flagella – extensions of a cell that are fewer, longer, and more whiplike than cilia

Introduction to Microbiology Algae ◦ Unicellular or multicellular ◦ Photosynthetic ◦ Simple reproductive structures ◦ Categorized on the basis of pigmentation, storage products, and composition of cell wall

Introduction to Microbiology Bacteria and Archaea ◦ Unicellular and lack nuclei ◦ Much smaller than eukaryotes ◦ Found everywhere there is sufficient moisture; some found in extreme environments ◦ Reproduce asexually ◦ Two kinds Bacteria – cell walls contain peptidoglycan; some lack cell walls; most do not cause disease and some are beneficial Archaea – cell walls composed of polymers other than peptidoglycan

The Golden Age of Microbiology Redi’s Experiments ◦ When decaying meat was kept isolated from flies, maggots never developed ◦ Meat exposed to flies was soon infested ◦ As a result, scientists began to doubt Aristotle’s theory

The Golden Age of Microbiology Pasteur’s Experiments ◦ When the “swan-necked flasks” remained upright, no microbial growth appeared ◦ When the flask was tilted, dust from the bend in the neck seeped back into the flask and made the infusion cloudy with microbes within a day

The Golden Age of Microbiology

The Golden Age of Microbiology

The Golden Age of Microbiology What Causes Disease? ◦ Pasteur developed germ theory of disease ◦ Robert Koch studied causative agents of disease Anthrax Examined colonies of microorganisms
The Golden Age of Microbiology Koch’s Experiments ◦ Simple staining techniques ◦ First photomicrograph of bacteria in diseased tissue ◦ Techniques for estimating CFU/ml ◦ Use of steam to sterilize media ◦ Use of Petri dishes ◦ Aseptic techniques ◦ Bacteria as distinct species ◦ Koch’s Postulates

The Golden Age of Microbiology

The Golden Age of Microbiology How Can We Prevent Infection and Disease? ◦ Semmelweis and handwashing ◦ Lister’s antiseptic technique ◦ Nightingale and nursing ◦ Snow – infection control and epidemiology ◦ Jenner’s vaccine – field of immunology ◦ Ehrlich’s “magic bullets” – field of chemotherapy

The Golden Age of Microbiology

The Modern Age of Microbiology

The Modern Age of Microbiology What Are the Basic Chemical Reactions of Life? ◦ Biochemistry Began with Pasteur’s work on fermentation and Buchner’s discovery of enzymes in yeast extract Kluyver and van Niel – microbes used as model systems for biochemical reactions Practical applications Design of herbicides and pesticides Diagnosis of illnesses and monitoring of patients’ responses to treatment Treatment of metabolic diseases Drug design

The Modern Age of Microbiology How Do Genes Work? ◦ Microbial genetics ◦ Molecular biology ◦ Recombinant DNA technology ◦ Gene therapy

The Modern Age of Microbiology Recombinant DNA Technology ◦ Genes in microbes, plants, and animals manipulated for practical applications ◦ Production of human bloodclotting factor by E. coli to aid hemophiliacs Gene Therapy ◦ Inserting a missing gene or repairing a defective one in humans by inserting desired gene into host cells

The Modern Age of Microbiology What Role Do Microorganisms Play in the Environment? ◦ Bioremediation uses living bacteria, fungi, and algae to detoxify polluted environments ◦ Recycling of chemicals such as carbon, nitrogen, and sulfur

The Modern Age of Microbiology How Do We Defend Against Disease? ◦ Serology The study of blood serum Von Behring and Kitasato – existence in the blood of chemicals and cells that fight infection ◦ Immunology The study of the body’s defense against specific pathogens ◦ Chemotherapy Fleming discovered penicillin Domagk discovered sulfa drugs

The Modern Age of Microbiology What Will the Future Hold? ◦ Microbiology is built on asking and answering questions ◦ The more questions we answer, the more questions we have

Worldwide Infectious Diseases Affecting Health Sciences Increasing number of drug resistant strains including Nosocomial and Community Acquired microorganisms MRSA Methicillin Resistant Staphylococcus aureus VRE Vancomycin Resistant Enterococcus VRSA Vancomycin Resistant Staphylococcus aureus MDR-TB Multidrug Resistant Tuberculosis

Worldwide Infectious Diseases Affecting Health Sciences Increasing number of emerging diseases (SARS, AIDS, hepatitis C, viral encephalitis) Other diseases previously not linked to microorganisms now are (gastric ulcers, certain cancers, multiple sclerosis)

Cellular Organization Prokaryotic Eukaryotic

Definition of Life What characteristics must an organism have in order to considered alive? Metabolism: Transformation of energy by converting chemicals and energy into cellular components (anabolism) and decomposing organic matter (catabolism). Living things require energy to maintain internal organization (homeostasis) and to produce the other phenomena associated with life. Reproduction: The ability to produce new individual organisms either asexually, from a single parent organism, or sexually, from at least two parent organisms.

Types of Microorganisms Based on Acquiring Nutrition Autotrophic Heterotrophic Saprophytic or Saprobic

Viruses Not independently living cellular organisms Much simpler than cells- basically a small amount of DNA or RNA wrapped in protein and sometimes by a lipid membrane Individuals are called a virus particle or virion Depend on the infected cell’s machinery to multiply and disperse

Taxonomy: Naming, Classifying, and Identifying Microorganisms Microbial nomenclature- naming microorganisms Taxonomy- classifying living things Identification- discovering and recording the traits of organisms so they can be named and classified

Traditional Whittaker Classification Five Kingdoms Prokaryotae (Monera) Protista Fungae Plantae Animalia Based on: Morphology Metabolism (Biochemical Activity) Molecular Techniques Fatty Acid Profiles Protein Differentiation DNA Finger Printing

Classification Woese-Fox Classification Three Super Kingdoms Eubacteria Archaeabacteria Eukarya System is based on r. RNA.

Assigning Specific Names The binomial system of nomenclature ◦ The generic (genus) name followed by the species name ◦ Generic part is capitalized, species is lowercase ◦ Both are italicized or underlined if italics aren’t available Staphylococcus aureus

The Origin and Evolution of Microorganisms Phylogeny- the degree of relatedness between groups of living things Based on the process of evolutionhereditary information in living things changes gradually through time; these changes result in structural and functional changes through many generations Ø Two preconceptions: All new species originate from preexisting species Closely related organisms have similar features because they evolved from a common ancestor Ø Phylogeny usually represented by a tree- showing the divergent nature of evolution
beec9461e662a439e3bb6cf2cdda3e91.ppt